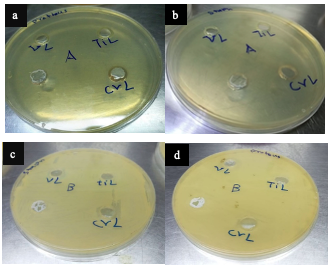
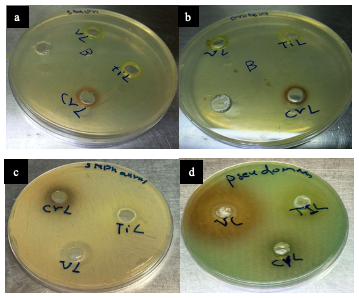

|
Introduction As a result of the vast diversity of transition metal coordination chemistry, prospects for the design of coordination compounds, in more recent times, have been a subject of great interest [1]. The pharmacological activity of these metal compounds depends on the metal ions, ligands, and the structure of the compounds [2]. These factors are partly responsible for the ability of these coordination compounds to locate the proper target site of activity and, consequently, their pharmacological activity [3]. It is known that certain metal ions penetrate through bacteria cell walls, in the form of complexes, into the cell and inactivate certain enzymes, thus killing such bacteria [4]. Through the synthesis of organic ligands containing various donating groups, coordination chemistry is constantly expanding, and it grows in importance, particularly when these ligands possess biological significance [5]. Amino acids are a distinct class of organic compounds and serve as components of chiral compounds (except glycine), so they play a crucial role in biochemical processes within living organisms [6]. β-Lactam antibiotics have been successfully used in the treatment of infectious diseases for many years, and compounds containing a β-Lactam ring are a class of important compounds in the medicinal and pharmaceutical field. Since the discovery of β- Lactam antibiotics in 1907 by Scantest and its clinical introduction as an anti-bacterial agent in the early 1950s [7], β-lactam antibiotics have remained the most popular drugs for treating bacterial infections of many diseases [8]. Since that time, the biological applications of these compounds have attracted remarkable attention, partic- ularly 6-aminopenicillin [9]. 6-Amino-penicillin acid is the most widely used class of antimicrobial agents [10]. This acid has been shown to exert pronounced biological effects on various bacterial strains [11]. Ibtisam M. Ali et al. (2021) utilized Schiff bases and 6-amino penicillanic acid (6- APA) to create azomethine ligands (HL1, HL2, HL3, and HL4). These ligands were complexed with four fresh ligands of copper (II), nickel (II), and iron (II) metal ions, forming octahedral complexes. The synthesized ligands and their complexes exhibited strong biological activity [14]. N. Ghufran Kareem et al. (2021) prepared a novel azo-azomethine ligand [6{2-hydroxy- 4-((3-nitrophenyl)diazenyl)-1-phenyl}imine penicillanic acid] (HNDIP) through the interaction of [2-hydroxy-4-(3-nitro- phenyl)diazenyl] benzaldehyde with 6- aminopenicillanic acid (6-APA). The ligand was then complexed with Cu(II), Ni(II), Co(II), Zn(II), and Fe(II) metal ions. These complexes were identified using FTIR, UV- Vis, molar conductance, magnetic sensitivity theory, and atomic absorption analysis [15]. In another study, Haneen Saadi et al. (2023) prepared three novel ligands by reacting 6- amino penicillin acid (6-APA) with aromatic amines to synthesize triazene ligands L1, L2, and L3. The complexes were then prepared by reacting these ligands with copper (II), cadmium (II), and zinc (II). The resulting bonds facilitated the formation of dimeric complexes [17]. Titanium is the ninth most abundant element in the earth's crust and the fourth most abundant element. Its elemental abundance is about five times less than iron and 100 times greater than copper [18,19]. Vanadium is a trace metal that is found naturally, both in soil and water [20]. Vanadium com- pounds have been prepared in many oxidation states, three of which are vanadium(III), (IV), and (V) [21].The catalytic activity of vanadium compounds and their role in biological systems chromium (Cr), a chemical element of Group 6 (VIb) of the periodic table, is a hard steel-gray metal that takes a high polish and is used in alloys to increase strength and corrosion resistance. Chromium was discovered in 1797 by the French chemist Nicolas-Louis Vauquelin and isolated as a metal a year later [22]. In another study, Tabark Mohammed et al. (2024) synthesized three novel ligands by reacting 6-amino penicillin acid (6-APA) with aromatic amines to produce triazene ligands L1, L2, and L3. The complexes were subsequently prepared by reacting these ligands with chromium (III), vanadium (III), and titanium (III) metals. The resulting bonds facilitated the formation of dimeric complexes with octahedral geometry. The synthesized ligands and their complexes demonstrated good biological activity [23] Staphylococcus aureus is a gram-positive spherically-shaped bacterium, a member of the Bacillota phylum, and is a usual member of the microbiota of the body, frequently found in the upper respiratory tract and on the skin. It is often positive for catalase and nitrate reduction and is a facultative anaerobe, meaning that it can grow without oxygen [24]. Although S. aureus usually acts as a commensal of the human microbiota, it can also become an opportunistic pathogen, being a common cause of skin infections including abscesses, respiratory infections such as sinusitis, and food poisoning [25]. Pseudomonas aeruginosa is a common encapsulated, gram-negative, aerobic–facultatively anaerobic, rod-shaped bacterium that can cause disease in plants and animals, including humans [26]. It is a species of significant medical importance, known for being a multidrug-resistant pathogen. It is recognized for its widespread presence and advanced mechanisms of antibiotic resistance, which are associated with serious illnesses, including hospital-acquired infections such as ventilator-associated pneumonia and various sepsis syndromes. P. aeruginosa can selectively prevent certain antibiotics from penetrating its outer membrane, contributing to its high resistance to multiple antibiotics. According to the World Health Organization, P. aeruginosa represents one of the greatest threats to human health in terms of antibiotic resistance [27].
Experimental Chemicals 6-Amino penicillanic Acid, Purity 99.98%, Chemical Formula C8H12O3N2S, Company Sigma-Aldrich, Ethanol C2H5OH, Purity 99.98%, Chromium (III) Chloride CrCl3, Purity 97.98%, Titanium (III) Chloride TiCl3, Purity 97.88%, Vanadium (III) Chloride VCl3, Purity 97.98%, Company BDH.Study Mole Ratio The mole-ratio way was followed to determine the metal:ligand [M:L] ratio in absolute ethanol as solvent. The data suggested that the metal-to-ligand ratio [M:L] was [2:1] for complexes. Synthzesis of Metal-Ligand Complexes The complex was prepared by the following procedure: 1:2 ratio (metal:ligand) 0.50 gm (0.002 mole) of 6-APA was mixed with 20 ml of absolute ethanol. It was completely dissolved by heating at a temperature of (30- 40°C), and then 0.001 mole of the salts TiCl3, VCl3 and CrCl3 (0.28 ml, 0.27 g, 0.25 g) were, respectively, dissolved successively with 5 mL of ethanol and serially added, step by step, to the 6-APA solution, with a noticeable color change upon addition. The mixture was stirred continuously for two hours after the reaction was completed. The complex solution was dried at 25°C. The precipitate colors of the complexes that were formed differed from the original materials, and pure ethanol was used for washing and recrystallization to get rid of impurities, as shown in Table 1 and Figure 1. To describe the synthesis of the three complexes by the chemical equations 1-3.
Evaluation of Antibacterial Activity The in vitro biological screening effects of the investigated compounds were tested against the bacteria (Staphylococcus aureus, Pseudomonas aeruginosa). This was carried out by the disk diffusion technique, using agar nutrient as the medium [28]. The stock solution (1×10-6 M,1×10-3 M) of new complexes was prepared by dissolving the compounds in DMSO. In a standard procedure, a well was created in an agar medium that had been inoculated with microorganisms. Using a micropipette, the test solution was added to the well, and the plate was then incubated for 24 hours at 37°C. During this incubation period, the test solution was diffused and impacted the growth of the inoculated microorganisms. Afterward, the diameter of the inhibition zone was measured. Molecular Docking (Salmonella typhi) As an Against Typhoid Fever-Causing Agent Molecular docking was utilized to estimate the binding mechanism between 6-amino- penicillin acid and the Salmonella typhi enzymes that are involved in bacterial mem- brane proteins (PDB ID: 5I5F). The crystal- lographic structure of the 6-aminopenicillin acid was obtained from the Material Project database in CIF format. Subsequently, the transformation of these crystallographic structures into 3D was performed by Avogadro software and saved as an a. mol2 data file. One type of protein from Salmonella typhi was selected (PDB ID: 5I5F) to evaluate the effect of 6-aminopenicillin acid on the protein selected for molecular docking.
Results and Discussion Sample Characterization FT-IR spectrum The FTIR spectra provided valuable information regarding the nature of the func- tional group attached to the metal atom [29]. The most important infrared spectral bands that provided conclusive structural evidence for the coordination of the ligand to the central metal ions are given in Table 1. The FT-IR spectrum of the ligand shows char- acteristic bands at 3525 cm-1 due to the (N- H) functional group [30]. The (N-H) and band in the free ligand shift for the complex; these shifts confirm the coordination of the ligand via the nitrogen of the amine group to metal ions [31]. The absorption band in ligand 6-APA observed at 1773 cm-1 is attributed to the υβ(C=O); this band changed in the spectra of their complexes [32]. New bands are attributed to the appearance of υ(M-N) and (M-O) vibrations in all complexes. It was established that the ligand functions as a bidentate ligand, coordinating with metal ions through the oxygen atom of the carbonyl group in β-lactam and the nitrogen atoms of the imine groups. Table 2 presents the main absorption values observed in the spectra of the prepared compounds, while Figure 2 displays the FT- IR spectrum of these compounds.
Electronic spectra In ethanol absolute solution, the electronic spectrums of complexes were determined to be between 200-1100 nm at room temperature [33]. The UV-visible spectra of the ligand include absorption peaks at wave- lengths 280 nm n-𝛑* transition for the non-bonding pair of electrons of a nitrogen amine group. The UV-Vis spectrum of complexes exhibits two peaks due to the (C.T) [34]. The UV-Vis data of ligands and complexes are reported in Figure 3 and Table 3.
Mass spectroscopy for the complex of Ti(III) A peak in the complex of Ti(III) mass spectrum appeared at 585.7, attributed to the parent molecular ion. Figure 4 shows the mass spectrum for (Complex), correponding to the proposed molecular formula (586.74).
The spectrum recorded other peaks cor- responding to the Complex molecule's frag- ments. These peaks are listed in Table 4, where 549.75 for [Ti(APA)2Cl2]+ , 514.9 for [Ti(APA)2Cl]+ , 478.85 for [Ti(APA)2]+ , 434.8 for (APA)2 and 216.24 for (APA).
XRD The X-ray diffraction (XRD) patterns of three complexes (L-V, L-Cr, and L-Ti) were analyzed. The results indicate that none of the three complexes exhibit a crystalline structure, as illustrated in Figure 5. Peaks observed at 2θ values of 19.12° and 26.24° suggest a transition from an amorphous state.
The broad peak noted in the complexes confirms the involvement of ligand grafting with the metal. The broadness of the XRD patterns indicates the dispersion of the metal within the ligand. Additionally, the shifting of peaks to 2θ values of 22.12° and 28.12° suggests the presence of non-crystalline planes. A comparative analysis of the three complexes reveals shifts in the diffraction peaks and a reduction in crystallinity. Magnetic Susceptibility For coordination complexes, the Magnetic Susceptibility properties of all complexes were measured and compared with the literature, which has been reached from the vacuum of these complexes and was found to be an octahedral shape. Atomic Absorption The atomic absorption of the transition metal complexes was measured, and the experimental results closely matched the theoretical values. This consistency supports the accuracy of the proposed formulas and the mixing ratios between the metals and ligands in the complex structure. Molar Conductivity
Looking at the molar conductivity results using ethanol absolute as a solvent at a concentration (0.003M), it has been found that all complexes are conductive (the behavior of these complexes was conductive) [35]. According to these results and those obtained from the IR study, an octahedral geometry around Ti (III), V(III), and Cr(III) ions can be suggested, as shown in Table 5 and Figure 6.
Biological Activity for the Complexes Several factors influence the biological activities of ligands and metal ion complexes. These factors include the type of ligand, the specific metal ion, the electron configuration of the metal ions, the transition series, and the geometry of the complexes. The results of the biological activity tests for the prepared metal complexes are presented in Table 6. For each treatment, we measured the diameter of the inhibition zone (including the disk diameter) in millimeters. The complexes demonstrated maximum antibacterial activity against all the organisms used in this study [36].
A: At a lower concentration, such as 1×10-6 M, the inhibition of bacterial growth was found to be minimal. This suggests that the complex has a limited ability to prevent the growth of bacteria at this concentration. However, B: when the concentration was increased to 1×10-3 M, a stronger inhibitory effect was observed against both Gram- positive and Gram-negative bacteria [37], as shown in Figures 7 and 8.
Molecular Docking This study aims to understand how the ligand 6-aminopenicillin acid inhibits the enzymes and transcriptional regulatory receptor proteins of Salmonella typhi through molecular docking analyses. Initially, a model protein was created, allowing for the evaluation of its geometric conformations and stereochemical quality using various structural validation algorithms. The VADAR tool was utilized to assist in calculations for generating the Ramachandran plot. Auto Dock 4.2.6 was employed to simulate the molecular docking of all target compounds with 6-amino-penicillin acid [31]. This powerful in silico approach modeled atom-level interactions between the ligand (6-aminopenicillin acid) and the receptor proteins, elucidating their behavior within the binding sites. A total of 50 active sites were identified, with the largest one selected for further analysis of its docking interactions with each protein. Active sites are the pockets or grooves that serve as functional indicators of a protein's role. Typically constituting only 10%–20% of a protein's volume, these sites are crucial as they directly facilitate binding reactions. The docking results (see Figure 9) indicated that one enzyme, 5I5F from Salmonella typhi, exhibited energy values of -5.02 [32].
Conclusion The synthesis of titanium, vanadium, and chromium ion complexes using 6-aminopenicillin acid as a ligand resulted in the formation of novel compounds with unique chemical structures. These complexes were characterized through various analytical techniques, which confirmed their successful synthesis. Furthermore, they demonstrated significant biological activity against both Staphylococcus aureus (Gram- positive bacteria) and Pseudomonas aeruginosa (Gram-negative bacteria), indicating their potential as effective antibacterial agents. This research opens avenues for the development of new metal-based antimicrobial drugs, particularly in response to the increasing resistance of bacteria to traditional antibiotics. The findings suggest that 6-aminopenicillanic acid is a promising candidate for multiple applications, such as biofilm control, antimicrobial treatment, antioxidant activity, and environmental pollution mitigation. To explore the molecular interactions of 6-amino-penicillanic acid, molecular docking studies were conducted to evaluate its binding with Salmonella global domain 191 proteins.
References
|